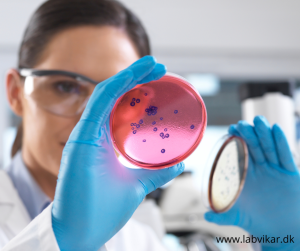

BESAT: Laborant til virksomhed i Frederikssund
Vi søger for vores kunde en laborant til et 3 måneders vikariat på fuld tid.
Der kan være mulighed for forlængelse af vikariatet.
Vi ønsker en laborant, som kan starte med det samme.
Har du erfaring indenfor elementær mikrobiologi – udsåning, dybdeudsæd, udtagning af prøver i produktionen, svaberprøver, vandprøver, arbejde i LAF bænk, fremstilling af substrater, simpel mikroskopi, membran filtrering etc. så modtager vi meget gerne din ansøgning.
Send din ansøgning til katja@labvikar.dk og husk at du skal være fuldt oprettet i vores database for at komme i betragtning.
Opret dig i vores database her: Bliv LabVikar – LabVikar
Se tjekliste her: Tjekliste – LabVikar
LabVikar ApS
Avernakøvænget 4
5000 Odense C